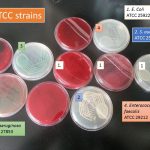
Microbial Quality Control Strains: Introduction, Application and Related Terms

Collection Group: Clinical Bacteriology
Salt Tolerance Test: Introduction, Principle, Procedure and Result Interpretation
 Introduction of Salt Tolerance Test The salt tolerance test is useful...
Introduction of Salt Tolerance Test The salt tolerance test is useful...
Bile Sample Gram Stain: Introduction, Procedure and Result Interpretation
 Introduction of Bile Sample Bile sample in Gram-stained smear has...
Introduction of Bile Sample Bile sample in Gram-stained smear has...
Microbial Quality Control Strains: Introduction, Application and Related Terms
Common Microbial ATCC Strains or Microbial Quality control strains Microbial...
Common Microbial ATCC Strains or Microbial Quality control strains Microbial...
